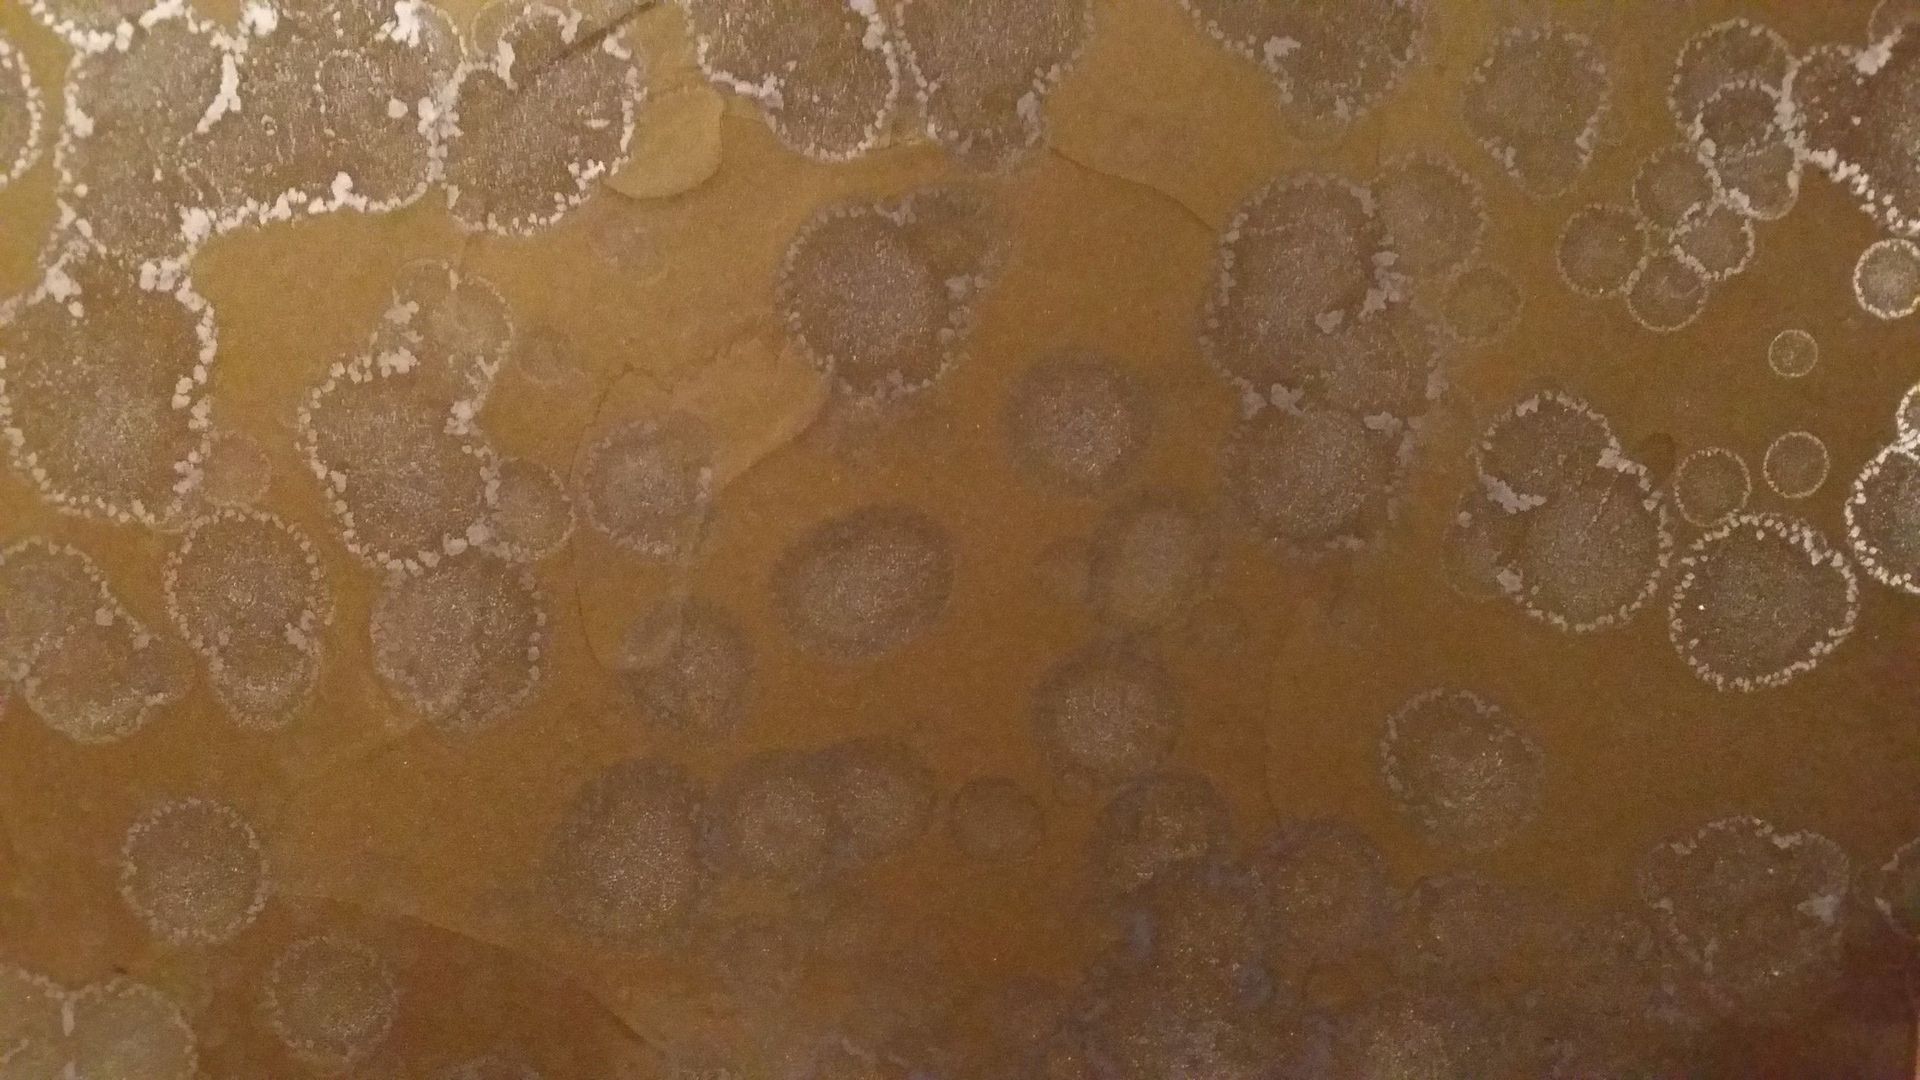
Tecniche decorative di stuccatura con resina - Lauricolor

Copertura
Lavori di pittura
Applicazione di carta da parati
Cornici
Velature per legno
Pitture per pavimenti
Tecniche decorative
Tecniche di spatolatura
Facciate
Rivestimenti decortativi in resina su mobili
Tecniche decorative per pavimenti duri
Tecniche decorative di stuccatura con resina
Lavori di gessatura